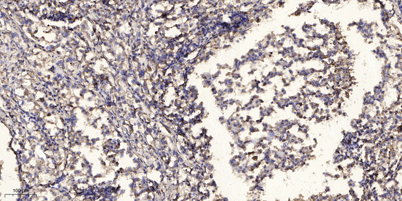

TIGD1 rabbit pAb
 One-click to copy product information
One-click to copy product information$148.00/50µL $248.00/100µL
| 50 µL | $148.00 |
| 100 µL | $248.00 |
Overview
| Product name: | TIGD1 rabbit pAb |
| Reactivity: | Human;Rat;Mouse; |
| Alternative Names: | TIGD1; Tigger transposable element-derived protein 1 |
| Source: | Rabbit |
| Dilutions: | WB 1:500-2000;IHC-p 1:50-300; ELISA 2000-20000 |
| Immunogen: | The antiserum was produced against synthesized peptide derived from human TIGD1. AA range:251-300 |
| Storage: | -20°C/1 year |
| Clonality: | Polyclonal |
| Isotype: | IgG |
| Concentration: | 1 mg/ml |
| Observed Band: | 67kD |
| GeneID: | 200765 |
| Human Swiss-Prot No: | Q96MW7 |
| Cellular localization: | Nucleus . |
| Background: | The protein encoded by this gene belongs to the tigger subfamily of the pogo superfamily of DNA-mediated transposons in humans. These proteins are related to DNA transposons found in fungi and nematodes, and more distantly to the Tc1 and mariner transposases. They are also very similar to the major mammalian centromere protein B. The exact function of this gene is not known. [provided by RefSeq, Jul 2008], |
-
 Western Blot analysis of 293 cells using TIGD1 Polyclonal Antibody diluted at 1:500. Secondary antibody(catalog#:RS0002) was diluted at 1:20000 cells nucleus extracted by Minute TM Cytoplasmic and Nuclear Fractionation kit (SC-003,Inventbiotech,MN,USA).
Western Blot analysis of 293 cells using TIGD1 Polyclonal Antibody diluted at 1:500. Secondary antibody(catalog#:RS0002) was diluted at 1:20000 cells nucleus extracted by Minute TM Cytoplasmic and Nuclear Fractionation kit (SC-003,Inventbiotech,MN,USA). -
 Western blot analysis of TIGD1 Antibody. The lane on the right is blocked with the TIGD1 peptide.
Western blot analysis of TIGD1 Antibody. The lane on the right is blocked with the TIGD1 peptide. -
 Western blot analysis of the lysates from HeLa cells using TIGD1 antibody.
Western blot analysis of the lysates from HeLa cells using TIGD1 antibody. -
Immunohistochemical analysis of paraffin-embedded human Squamous cell carcinoma of lung. 1, Antibody was diluted at 1:200(4° overnight). 2, Tris-EDTA,pH9.0 was used for antigen retrieval. 3,Secondary antibody was diluted at 1:200(room temperature, 45min).
Immunohistochemical analysis of paraffin-embedded human Squamous cell carcinoma of lung. 1, Antibody was diluted at 1:200(4° overnight). 2, Tris-EDTA,pH9.0 was used for antigen retrieval. 3,Secondary antibody was diluted at 1:200(room temperature, 45min).

 Manual
Manual